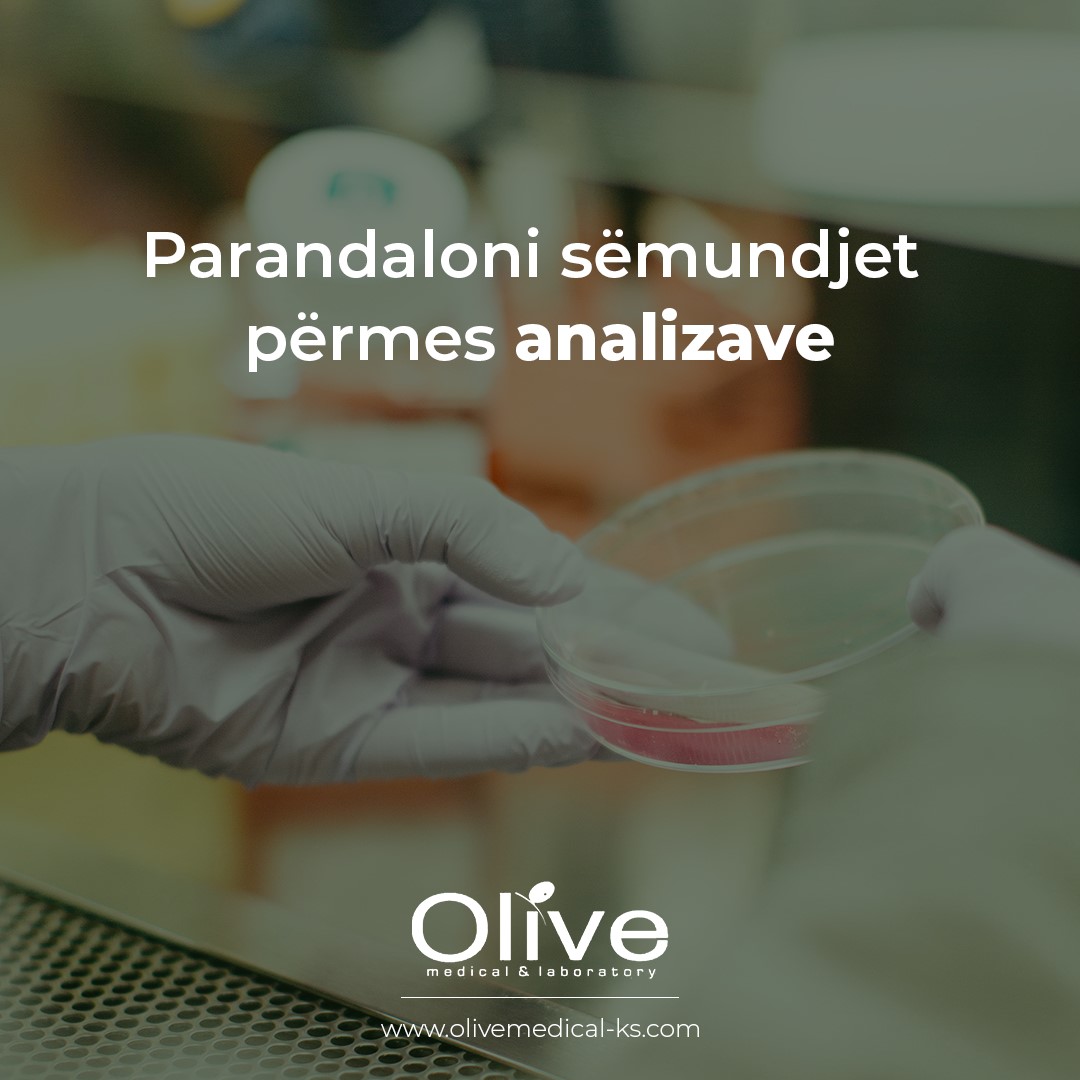

Nga një sondazh i bërë, doli në pah se 68% e të rriturve nuk janë në dijeni të kohës së rekomanduar të ushtrimit që duhet të bëjnë fëmijët e tyre. Më shumë se dy të tretat e prindërve nuk e dinë se sa duhet të bëjnë stërvitje fëmijët për të qëndruar të shëndetshëm.Udhëzimi zyrtar i NHS thotë se fëmijët e moshës nga pesë deri në 18 vjeç duhet të bëjnë një orë stërvitje çdo ditë.Sondazhi i 2.000 të rriturve nga YouGov për Trustin e Sportit Rinor (YST) zbuloi se vetëm një e katërta e dinin kohën e rekomanduar të ushtrimit për të rinjtë dhe mesatarisht njerëzit mendonin se ishte 46 minuta.Shefi ekzekutiv i YST, Ali Oliver, tha: “Ne kemi parë një tendencë shqetësuese në vitet e fundit të rënies së aktivitetit fizik të të rinjve dhe një shtytje në kohë të caktuar për edukim fizik të kualitetit të mirë”. Vitin e kaluar u raportua se nxënësit po merrnin mësimet e PE për t’u dhënë më shumë kohë për përgatitjen e provimeve dhe 38% e mësuesve të shkollave të mesme thanë se koha e PE-së për 14 deri në 16-vjeçarët kishte rënë gjatë vitit të kaluar.Ndërkohë, shifrat treguan se vetëm 17.5% e fëmijëve po godasin caqet 60-minutëshe të përditshme. Ata gjithashtu zbuluan një pabarazi në mes të fëmijëve me prejardhje të ndryshme ekonomike, me 39% të familjeve më të varfra duke bërë më pak se 30 minuta stërvitje në ditë, krahasuar me 26% nga familjet e pasura.Mirëpo, për të pasur një shëndet të mirë si fizik ashtu dhe mendor, prindërit duhet të vtëdijësohen që sporti, stërvitjet luajnë një rol kyç.

Hemostaza është një proces kompleks, që normalisht aktivizohet menjëherë pas dëmtimit të murit të vazës të gjakut dhe që siguron ndërprerjen e rrjedhjes se gjakut (hemoragjinë) dhe më pas rivendosjen e qarkullimit në këtë vazë pas rindërtimit të dëmtimit. Ajo përfshin ndërveprimet e enëve të gjakut (strukturat e mureve të gjakut dhe qelizave endoteliale që veshin nga brënda këto enë) dhe gjakut (trombocitet dhe faktorët e koagulimit).Hemostaza normale siguron shmangien e humbjes së menjëhershme të gjakut, humbje që në varësi të përmasave dhe llojit të vazave (arterie, venë, kapilar) mund të jetë nga sasi të vogla (të parrezikshme për jetën) deri në sasi të mëdha dhe për një kohë të shkurtër, me rrezikimin e jetës si pasojë e anemisë dhe pakësimit të volumit (ku në të tilla raste do të duhet dhe ndihma e mjekut dhe e medikamenteve). Zhvillohet në mënyrë natyrale, të pavetëdijshme (pra ne nuk mund ta nxisim ose ta frenojmë me dëshirën tonë).Endoteli i vazës së gjakut është mjaft i lëmuar, kusht i domosdoshëm për qarkullimin pa pengesa të gjakut. Nëse endoteli dëmtohet (atheroskleroza, vaskuliti etj), pra prishet lëmueshmëria e tij, aktivizohet procesi i koagulimit me pasojë formimin e trombit.
Hemostaza përfshin:
• Hemostazën primare
• Koagulimin
• Fibrinolizën
Hemostaza primare, ndodh menjëherë pas dëmtimit dhe konsiston në: ngushtimin e lumenit të vazës së gjakut (vazokonstriksioni) dhe formimin e trombit primar ose trombit trombocitar.Kur dëmtohet vaza e gjakut, jashtë murit të vazës, do të dali gjaku me të gjithë përbërësit e tij (qelizat dhe plazma). Vaza e gjakut, në sajë të elasticitetit të murit, ngushtohet dhe nese kalibri i vazes është i vogël, mund të çojë në ndërprerjen e hemoragjisë.Menjëhere do të futen në veprim trombocitet, të cilët do të adezohen (ngjiten) me murin e vazes së gjakut të dëmtuar. Faktori më i rëndësishëm i adezimit është faktori von Willebrand (vWF), që siguron lidhjen midis përbërsve të murit të vazës së gjakut dhe receptorit GP-1b, që ndodhet ne sipërfaqen e trombocitit. Mungesa e këtij faktori jep sëmundjen e von Willebrand . Mbas adezimit nga veprimi i faktorëve stimulues si PgI2, Trombina II do të çojë në çlirimin e kalçiumit që ndodhet brënda trombociteve me pasojë aktivizimin e sistemit aktinë-miozinë, rrjedhimisht do të ketë ndryshim të formës së trombocitit dhe çlirimin e përmbajtjes së granulave të trombocitit, ku elementet më të rëndësishëm janë ADP, serotonina etj. Faza tjeter është agregimi pra realizimi i lidhjeve të forta trombocit-trombocit dhe në këtë mënyrë formohet trombi primar ose trombi trombocitar, që është i tretshëm, por kur kalibri i vazës është i vogël mund të japi ndalim të hemoragjisë.Pra hemostaza primare konsiston në bashkëveprimin e vazës së gjakut me trombocitet dhe përfshin adezim te trombociteve, ndryshimin e formës se tyre, sekretim të përmbajtjes së granulave të trombociteve dhe agregimin e trombociteve duke çuar në formimin e një trombi primar ose trombi trombocitar.
Për të vlerësuar këtë fazë shërbejnë këto teste:
1. Koha e hemoragjisë /koha e gjakderdjes . Është koha që duhet për të formuar trombin trombocitar. Koha e hemorragjisë, vlerëson cilësinë, numërin e trombociteve si dhe elasticitetin e murit të vazës së gjakut. Më shpesh në praktikë përdoret koha e gjakderdhjes 1-4’ (mesatarisht 3’). Shpohet lapra e veshit dhe çdo 30” me një letër thithëse preket (jo fshihet) pika e gjakut, derisa të mos ngelet më njollë gjaku tek letra. Para se të bëhet KH, duhet pyetur pacienti për medikamentet që merr Aspirina nuk duhet marrë deri në 2 javë para bërjes së testit.
2. Agregimi i trombociteve bëhet me agregometer.Numërimi i trombociteve dhe vlerësimi i morfologjise se tyre. Pra, kërkohet, jo vetëm sa është numri i trombociteve (144.000-444.000 mm3), por dhe struktura dhe funksioni i tyre. Kjo shikohet kur bëhet vlerësimi i tyre në strishon e gjakut periferik të marrë me antikoagulant dhe në strishon pa antikoagulant (atë të formulës leukociare) ku shihet nëse trombocitet gjenden ose jo të vendosura në grupe.Ka metoda të ndryshme për numërimin e trombociteve, secila me avantazhet dhe disavantazhet e saj, por numërimi i trombociteve në strishot e gjakut periferik te përgatitura mirë dhe nga një mjek me eksperiencë është vlerësimi më i mirë i numërit të trombociteve në krahasim me çdo metodë tjetër (optical particle counter).Elementet më të rëndësishme në hemostazën primare janë; vaza e gjakut, numëri dhe funksioni i trombociteve dhe vWF (komponent i plazmës). Nëse secila prej tyre dëmtohet, për shkaqe të lindura ose të fituara, hemostaza primare do të dëmtohet, me pasojë hemoragjinë apo trombozat.
Faza e koagulimit (hemostaza sekondare). Pasi formohet trombi primar (trombocitar) gjatë hemostazës primare,
1. Proteinat inaktive të koagulimit (faktorët e koagulimit) që ndodhen në plazmë aktivizohen në formë kaskade, progresive (njëra pas tjetrës) dhe hemostaza sekondare fillon, për të përfunduar 3-6 minuta më vonë me formimin e trombit hemostatik ose të trombit përfundimtar . Faktorët e koagulimit (proteina ose glukoproteina) janë në gjëndje inaktive në kushte normale (nëse do të ishin gjithmonë në fazë aktive, pasoja është tromboza apo dhe hemoragjia nga konsumi i tyre .Gjithsejt janë 13. Tek faktorët e koagulimit përfshihen dhe kininogjeni me peshë të madhe molekulare, prekalikreina, plazminogjeni, proteina C. Jonet e Ca2+ janë shumë të rëndësishëm në aktivizimin e faktorëve të koagulimit.Të gjithë faktorët e koagulimit pa përjashtim janë shumë të rëndësishme. Dëmtimet sasiore apo cilësore të secilit prej tyre, të lindura apo të fituara, është baraz me një sëmundje trombotike ose hemoragjike dhe në disa raste dhe të dyja së bashku siç ndodh në KID (Koagulimi Intravaskular i Diseminuar). Shumica e tyre sintetizohen në hepar (kujdes sëmundjet e heparit) dhe faktorët II, VII, IX , X proteina C janë Vitaminë K-dependente (pra aktivizohen nga Vit.K). Të gjithë këta faktorë zëvëndësohen duke dhënë plazmë dhe disa prej tyre më produkte të plazmës (si krioprecipitati apo koncentratet e pastra të faktorëve të ndryshëm të koagulimit).
2. Faza e koagulimit përbëhet nga rruga e jashtme, e brëndshme dhe e përbashkët e koagulimit.
• Rruga e brëndshme e koagulimit (Intrinsic Pathway) do të aktivizohet si pasojë e dëmtimit të murit të vazës së gjakut dhe ekspozimit të të kolagjenit, i cili me anë të kontaktit (dhe kininogjenit me peshë të madhe molekulare) do të aktivizojë faktorin e XII të koagulimit që më pas do të aktivizojë faktorët XI, IX dhe X (këtu luan rol të rëndësishëm faktori VIII).
• Rruga e jashtme e koagulimit (Extrinsic Pathway) do të aktivizohet si pasojë e dëmtimit të murit të vazës së gjakut dhe ekzpozimit të qelizave subendoteliale ndaj gjakut, për pasojë do të çlirohet faktori indor, i cili do të aktivizojë faktorin VII të koagulimit që do të veprojë direkt në aktivizimin e Faktorit X.
• Pra të dyja rrugët arrijnë në një pikë të përbashkët (aktivizimi i Faktorit X) dhe që këtu fillon rruga e përbashkët e koagulimit me pasojën përfundimtare kalimin e fibrinogjenit në fibrinë. Fibrina vendoset mbi trombin trombocitar të formuar gjatë hemostazës primare. Rrjeta e fibrinës stabilizohet nga faktori i XIII dhe përfundimisht do të formohet trombi sekondar, hemostatik ose përfundimtar, i fiksuar plotësisht tek vëndi i dëmtimit dhe që siguron ndërprerjen e hemoragjisë.
• Ndërkohë fillon rindërtimi i murit të vazës së gjakut të dëmtuar dhe të indeve të tjera përreth.
• PT evaluon faktoret e koagulimit VII, X, V, II, and I (fibrinogen).
• APTT vlerëson faktorët e koagulimit XII, XI, IX, VIII, X, V, II (protrombin), dhe (fibrinogjenin), si dhe prekallikrein (PK) dhe kininogenin me peshë të lartë molekulare (HK).
• Për factorët e koagulimit sasia vlerësohet me Factor Antigen Assay (për vWF : Ag) dhe cilësia, funksioni, aktiviteti me Factor Activity Assay (për VWF:RCo or VWF:Act). Bëhet fillimisht Factor Activity dhe pastaj nëse është e nevojshme dhe Factor Antigen (për proteinën S total dhe free).
Të gjitha këto teste mund t’i bëni në mënyrë shumë të saktë në Olive Medical & Laboratory!
Shkruan: Dr. Valbonë Blaku, staf në Olive Medical & Laboratory!

Sistemi endokrin është një rrjet i integruar që përbëhet nga gjëndra të ndryshme të vendosura në të gjithë trupin. Së bashku me sistemin nervor, sistemi endokrin kontrollon dhe rregullon shumë funksione të brendshme trupore. Ndërsa sistemi nervor përdor impulset nervore si një mjet kontrolli, sistemi endokrin përdor molekulat të lajmëtarëve kimik të quajtur hormone. Hormonet prodhohen, ruhen dhe sekretohen nga rrjeti i gjëndrave.
Hormonet ndikojnë në sistemet e shumta në të gjithë trupin, duke përfshirë zhvillimin e meshkujve dhe femrave karakteristikave seksuale, pjellorisë, rritja, konsumit të energjisë, tretje, shfrytëzimin e glukozës, përgjigje stresi, bilanci fluide / ujit, metabolizmin e eshtrave, dhe mirëmbajtjen e presionit të duhur të gjakut. Kur gjëndrat prodhojnë shumë ose tepër pak të një hormoni të caktuar dhe ndikojnë në këto procese, ai njihet si një çekuilibër i hormoneve. Disa nga këto kushte kanë emra të tillë si sindroma Cushing (e lidhur me kortizol të tepërt), sepse ato janë të lidhura me një grup tipik simptomash dhe komplikimesh.
Mosfunksionimi i nje gjëndërreje endokrine mund të ndodhë kur ka një problem me vet gjëndrrën, një problem në sistemin e reagimit , dhe / ose për shkak të mungesës së përgjigjes nga ana e indeve të synuara hormon-së. Një ulje në prodhimin e hormoneve mund të jenë të lidhura me trauma, dëmtimi nga sistemit imunitar, infeksionit, grumbullim nga qelizat e hormoneve-prodhimin nga një tumor, ose një mutacion trashëguar gjenit që ndikon në sasinë, cilësinë, ose struktura e hormoneve. Dështimi i një gjëndre për të prodhuar dhe liruar hormonet e mjaftueshme për të stimuluar gjëndrën e synuar për të prodhuar dhe nxjerrë hormonin e saj mund të zvogëlojë prodhimin.
Rritja e prodhimit të hormoneve mund të lidhet me një çekuilibër të sistemit të reagimeve të tilla si gjëndra e hipofizës, që prodhon shumë hormone të tillë si ACTH dhe prishjen e sistemit të reagimit. Rritja e prodhimit mund të jetë e lidhur me hyperplasia (zgjeruar gjëndra) ose një tumor i qelizave hormonit-prodhimin, por edhe mund të ndodhë për shkak të mungesës së përgjigjes së indeve, përdorimit mjekim, apo një gjendje të trashëguar.
Tumoret endokrine që prodhojnë hormone të tepërta janë përgjithësisht të vogla dhe zakonisht janë të mirë. Shumica e tyre janë të vendosura brenda gjëndrës së prekur dhe prodhojnë një lloj të vetëm të hormoneve. Rrallë, ata mund të jenë kancerogjene. Është gjithashtu shumë e rrallë që tumoret endokrine-ndërprerëse mund të jenë të gjetura diku tjetër në trup. Një tumor mund të shkaktojë simptoma për shkak të hormonit të tepërt qe është prodhuar, sepse rritja e tumorit mund te ul prodhimin e hormoneve të tjera në gjëndër, ose për shkak se madhësia e saj fizike shtyn kundër nervave dhe strukturat përreth.
Kushte më të trashëguara endokrine janë të rralla dhe janë të lidhura zakonisht me prodhimin mangët ose jofunksional të një hormoni të vetme apo hormoneve për prodhimin e një gjëndër të veçantë (për shembull, hypothyroidism kongjenitale). Megjithatë, ekzistojnë kushte gjenetike që prekin shumë gjëndra. Dy që janë identifikuar si të ndikojnë në disa gjëndra endokrine janë MEN-1 dhe MEN-2 (Multiple Endocrine Neoplasia, llojet 1 dhe 2). Këto kushte janë të lidhura me ndryshime në gjenet specifike, dhe ato rrisin rrezikun e jetës .Këto kushte lidhen me ndryshimet në gjenet specifike dhe rrisin rrezikun e jetës që njerëzit e prekur do të zhvillojnë tumoret në një ose më shumë gjëndra endokrine
Shembuj të çrregullimeve endokrine :
• Sëmundja Addison dhe pamjaftueshmëria veshkave
• Hiperplasia kongjenitale të veshkave (CAH)
• Sindromi Conn (hiperaldosteronizmi primar)
• Sindromi Cushing
• Diabetes mellitus
• Steriliteti
• Sëmundjet e paratiroidese
• Çrregullime hipofizike
• Anomalitë menstruale, duke përfshirë Sindromin Ovarian Polycystic (PCOS)
• Sëmundjet tiroide, duke përfshirë sëmundjen Graves, tiroiditis Hashimoto dhe kanceri tiroide
• Acromegalia
• Hiperplasia e qelizave C
• Diabetes insipidus
• Neoplazia e shumëfishtë endokrine e tipit 2 (MEN 2)
• Pheochromocytoma
• Hiperaldosteronizmi sekondar
• Mungesa e hormoneve të rritjes
• Sindromi Zollinger-Ellison
• Çrregullime të kohës dhe zhvillimit të pubertetit (p.sh., i parakohshëm etj)
Të gjitha hulumtimet e nevojshme për vendosjen e një diagnoze të saktë kur keni qrregullime në këtë sistem ju mund t’i bëni në Olive Medical Laboratory prandaj, besoni në më të mirët

Homocisteina është një aminoacid që është zakonisht i pranishëm në sasi shumë të vogla në të gjitha qelizat e trupit për shkak se trupi normalisht konverton shpejt homocisteinën në produkte të tjera. Meqenëse vitaminat B6, B12 dhe folati janë të domosdoshme për të metabolizuar homocisteinën, niveli i rritur i aminoacideve mund të jetë një shenjë e mangësisë në ato vitamina. Ky test përcakton nivelin e homocisteinës në gjak dhe / ose urinë.Homocisteinina e ngritur gjithashtu mund të jetë e lidhur me një rrezik më të lartë për sëmundje koronare të zemrës, goditje në tru, sëmundje vaskulare periferike (depozitat yndyrore në arteriet periferike) dhe ngurtësimin e arterieve (aterosklerozë). Nivele të larta të homocisteinës rrisin rrezikun e formimit të mpiksjes së gjakut në ene dhe mund të çojnë në sulm në zemër dhe goditje në tru. Janë propozuar disa mekanizma për mënyrën se si homocisteinina çon në rrezikun e sëmundjeve kardiovaskulare (CVD), por lidhjet direkte nuk janë konfirmuar.
Ekzistojnë gjithashtu disa studime që tregojnë se nuk ka përfitim ose ulje të rrezikut nga CVD me acid folik dhe shtesa të vitaminës B. Deri më tani, Shoqata Amerikane e Zemrës nuk e konsideron atë një faktor kryesor rreziku për sëmundjet e zemrës.
Një gjendje e rrallë e trashëguar e quajtur homocistinemia gjithashtu mund të rrisë ndjeshëm homocisteinën në gjak dhe urinë. Në Sh.B.A, të gjithë foshnjat testohen në mënyrë rutinore për metioninë të tepërt, një shenjë e homocistinurisë, si pjesë e shqyrtimit të tyre të porsalindur. Nëse testi i ekzaminimit të një fëmije është pozitiv, atëherë shpesh kryhen teste të homocisteinës në urinë dhe gjak. Për më shumë informacion, shihni pyetjet e zakonshme më poshtë.
Si përdoret testi i homocisteinës? Një mjek i kujdesit shëndetësor mund të urdhërojë një test homocisteinine për të përcaktuar nëse një person ka një mungesë të vitaminës B12 ose folate. Përqendrimi i homocisteinës mund të rritet para se B12 dhe testet e folateve janë anormale. Disa praktikantë të kujdesit shëndetësor mund të rekomandojnë testimin e homocisteinës tek individë të kequshqyer, të moshuar, të cilët shpesh thithin më pak vitaminë B12 nga dieta e tyre, dhe individë me ushqim të dobët, siç janë droga ose varur nga alkooli. Homocisteinina mund të porositet si pjesë e një hulumtimi i për njerëzit në rrezik të lartë për sulm në zemër ose goditje në tru. Mund të jetë e dobishme tek dikush që ka një histori familjare të sëmundjes së arterieve koronare, por asnjë faktor tjetër i njohur i rrezikut, siç është pirja e duhanit, presioni i lartë i gjakut ose mbipesha. Sidoqoftë, roli i saktë që luan homocisteinina në përparimin e sëmundjes kardiovaskulare nuk është vendosur, kështu që dobia e testit të shqyrtimit vazhdon të vihet në dyshim. Ekzaminimi rutinë, siç është ai i bërë për kolesterolin total, nuk është rekomanduar.
Kur urdhërohet testimi i homocisteines? Ky test mund të porositet kur një mjek dyshon se një person mund të ketë një mungesë të vitaminës B12 B6 dhe B9/ ose folate. Shenjat dhe simptomat fillimisht janë delikate dhe jospecifike. Njerëzit me mungesë të hershme mund të diagnostikohen para se të shfaqin ndonjë simptomë të qartë.
Njerëzit e tjerë të prekur mund të shfaqin një sërë simptomash të buta deri të rënda që mund të përfshijnë: diarre,marramendje,Lodhje, dobësi, Humbja e oreksit,zbehje, Shkalla e shpejtë e zemrës,Gulçim, Gjuha e lënduar dhe goja, Tingëllimë, mpirje, dhe / ose djegie në këmbë, duar, krahë dhe këmbë (me mungesë B12). Testimi i homocisteinës mund të porositet si pjesë e vlerësimit të rrezikut të një personi nga sëmundjet kardiovaskulare, në varësi të moshës së individit dhe faktorëve të tjerë të rrezikut. Mund të urdhërohet gjithashtu pas një sulmi në zemër ose goditje në tru për të ndihmuar udhëzimin e trajtimit.
Çfarë do të thotë rezultati i TESTIT? Në rastet e kequshqyerjes së dyshuar ose të mungesës së vitaminës B12 ose folate, nivelet e homocisteinës mund të ngrihen. Nëse një individ nuk merr mjaftueshëm vitamina B dhe / ose folate përmes dietës ose shtojcave, atëherë trupi mund të mos jetë në gjendje të shndërrojë homocisteinën në forma që mund të përdoren nga trupi. Në këtë rast, niveli i homocisteinës në gjak mund të rritet. AHA nuk rekomandon përdorim të gjerë të acidit folik dhe vitaminave B për të zvogëluar rrezikun e sulmit në zemër dhe goditje në tru, ai promovon një dietë të ekuilibruar, të shëndetshme dhe këshillon praktikuesit e kujdesit shëndetësor që të marrin parasysh faktorët e përgjithshëm të rrezikut dhe dietën.
A ka ndonjë gjë tjetër që duhet të dijmë? Kur rezultatet e testit sugjerojnë homocistinurinë, mostrat e biopsisë së mëlçisë ose të lëkurës ndonjëherë testohen për të përcaktuar nëse enzima cistathionine beta sinteza (CBS) është e pranishme. Mungesa e kësaj enzime është shkaku më i zakonshëm i homocistinurisë. Testet gjenetike mund të urdhërohen të testojnë për një ose më shumë nga mutacionet e gjeneve më të zakonshme. Nëse dikush ka një histori të fortë familjare të aterosklerozës së hershme ose një anëtar i familjes është diagnostikuar me homocistinuria, atëherë ai person duhet të testohet për mutacionin e gjenit që u gjet në anëtarin e familjes.Nivelet e homocisteinës mund të rriten me moshën, kur një person pi duhan, dhe me përdorimin e ilaçeve të tilla si karbamazepinë, metotreksate, dhe fenitoin. Nivelet e homocisteinës janë më të ulëta tek gratë sesa te burrat. Përqendrimet e grave rriten pas menopauzës, ndoshta për shkak të uljes së prodhimit të estrogjenit ,keqmenagjimit te sëmundjeve kardiovaskulare.
I porsalinduri duhet bërë një provë homocistineine. Pse? Një gjendje e rrallë e trashëguar e quajtur homocistinuria mund të rrisë shumë homocisteinën në gjak dhe urinë. Testet si për urinën ashtu edhe për homocisteinën e gjakut mund të përdoren për të ndihmuar në diagnostikimin e homocistinurisë nëse një mjek i kujdesit shëndetësor dyshon se një foshnjë ose një fëmijë mund të ketë këtë çrregullim të trashëguar. Nëse testi i ekzaminimit të një fëmije është pozitiv, atëherë shpesh kryhen teste të homocisteinës në urinë dhe gjak. Përqendrimet e rritura shumë të homocisteinës në urinë dhe gjak do të thotë që ka të ngjarë që një foshnjë të ketë homocistinurinë dhe tregon nevojën për testime të mëtutjeshme për të konfirmuar shkakun e rritjes.Në homocistinurinë, një nga disa gjene të ndryshme – më së shpeshti gjeni CBS (cistathionine beta synthase) alt ndryshohet, duke prishur funksionin e CBS. CBS është një enzimë që vepron në një rrugë biokimike dhe është përgjegjëse për shndërrimin e homocisteinës në një molekulë të quajtur cisteine. Si rezultat i mosfunksionimit të CBS, në trup krijohen metionina (një aminoacid), homocisteinina dhe substanca të tjera toksike toksike. Disa nga homocisteinat e tepërta ekskretohen në urinë (homocistinuria).
Ndërtimi i homocisteinës dhe substancave të tjera nënprodukte në trup çon në çrregullim multi-sistemik. Foshnjat me këtë gjendje do të shfaqen normale gjatë lindjes, por, nëse nuk mjekohen, ata brenda disa viteve do të fillojnë të zhvillojnë shenja të tilla si një lentë e zhvendosur në sy, një ndërtim i hollë i gjatë, gishtërinj të gjatë të hollë, anomalitë skeletore, osteoporoza, etj. dhe një rrezik të rritur shumë nga tromboembolizmi dhe nga ateroskleroza që mund të çojnë në sëmundje kardiovaskulare të parakohshme.Ndërtimi gjithashtu mund të shkaktojë aftësi të kufizuara intelektuale, sëmundje mendore, IQ pak të ulët, çrregullime në sjellje dhe konfiskime. Disa prej tyre mund të lehtësohen nëse gjendja zbulohet herët, kjo është arsyeja pse të gjitha shtetet shfaqin të posalindurit për homocistinuria.
Të gjitha analizat përcjellëse me saktësi mund të realizohen në Olive Medical & Laboratory
Shkruan: Dr. Valbone Blaku, specialiste e Mjekësisë Familjare, staf në Olive Medical & Laboratory.

Kaliumi është një elektrolit që është jetik për metabolizmin e qelizave. Ndihmon në transportimin e lëndëve ushqyese në qeliza dhe largon produktet e mbetjeve nga qelizat. Eshtë gjithashtu i rëndësishem në funksionin e muskujve, duke ndihmuar në transmetimin e mesazheve midis nervave dhe muskujve. Me test matet sasia e kaliumit në gjak dhe / ose urinë.Elektrolitet janë minerale që mbartin një ngarkesë dhe ekzistojnë në lëngjet e trupit . Kaliumi dhe elektrolitet e tjerë si natriumi, kloruri dhe bikarbonati (CO2 i plotë) ndihmojnë në rregullimin e sasisë së lëngjeve në trup dhe mban një ekuilibër të qëndrueshëm acid-bazë. Kaliumi është i pranishëm në të gjitha lëngjet e trupit, por shumica e kaliumit gjendet brenda qelizave. Vetëm një sasi e vogël është e pranishme në lëngje jashtë qelizave dhe në pjesën e lëngshme të gjakut (quhet serum ose plazmë).Ne e marrim shumicën e kaliumit që na nevojitet nga ushqimet që hamë. Shumica e njerëzve kanë një marrje adekuate të kaliumit. Trupi përdor atë kalium që i nevoitet , atëherë veshkat eliminojnë pjesën tjetër në urinë. Trupi përpiqet të mbajë nivelin e kaliumit në gjak brenda një diapazoni shumë të ngushtë. Nivelet kontrollohen kryesisht nga aldosteroni, një hormon i prodhuar nga gjëndrat mbiveshkore .Për shkak se përqendrimi i kaliumit në gjak është aq i vogël , ndryshimet e vogla mund të kenë efekte të konsiderueshme shëndetësore. Nivelet e kaliumit që janë shumë të ulëta ose shumë të larta mund të ndryshojnë funksionin e nervave dhe muskujve dhe mund të ketë komplikime serioze shëndetësore, të tilla si shoku, probleme të frymëmarrjes (dështimi i frymëmarrjes), rrahje të çrregullt të zemrës, ose muskuli i zemrës madje mund të humbasë aftësinë e tij të kontraktohet. Matja e kaliumit si pjesë e një elektroliti ose paneli metabolik mund të ndihmojë në diagnostikimin e një çekuilibri elektrolit acidozë ose alkalozë. Acidoza dhe alkaloza përshkruajnë kushtet anormale që rezultojnë nga një çekuilibër në pH e gjakut të shkaktuar nga një tepricë acidi ose alkali (baze). Kjo çekuilibër zakonisht shkaktohet nga ndonjë gjendje themelore ose sëmundje.
Një test i kaliumit ne gjak përdoret për të zbuluar nivele anormale të kaliumit, duke përfshirë kalium të lartë (hiperkalemia) dhe kalium të ulët (hipokalemia). Shpesh përdoret si pjesë e panelit elektrolit ose panelit themelor metabolik për një provim rutinë shëndetësor.Testi i kaliumit mund të përdoret gjithashtu:Për të ndihmuar në zbulimin, vlerësimin dhe monitorimin e çekuilibrave të elektroliteve dhe / ose zhbalancimeve acido-bazike (pH) (acidozë ose alkalozë). Për të ndihmuar në vlerësimin dhe monitorimin e një sërë sëmundjesh kronike ose akute, të tilla si presioni i lartë i gjakut ose sëmundja e veshkave, shkaku më i zakonshëm i kaliumit në gjak të lartë. Për të zbuluar vlera anormale kur keni diarre dhe të vjella ose djersitje të tepruar. Për të ndihmuar në përcaktimin e shkakut të simptomave që përfshijnë zemrën (p.sh., rrahje të parregullt të zemrës). Për të monitoruar efektet e ilaçeve që mund të bëjnë që veshkat të humbin kalium, veçanërisht diuretikët, ose ilaçe që ulin eliminimin e kaliumit nga trupi, i cili mund të rezultojë në një nivel të lartë të kaliumit.Nivelet e kaliumit në urinë mund të testohen tek njerëzit që kanë nivele anormale të kaliumit në gjak për të ndihmuar në përcaktimin e shkakut, siç është dehidrimi . Testimi i kaliumit në urinë përdoret gjithashtu për njerëzit me teste anormale të veshkave për të ndihmuar mjekun e kujdesit shëndetësor të përcaktojë shkakun e sëmundjes së veshkave dhe për të ndihmuar në drejtimin e trajtimit.
Niveli i kaliumit është një test themelor dhe mund të porositet kur keni një provim mjekësor rutinë ose kur vlerësoheni për një sëmundje të rëndë. Testimi mund të bëhet kur keni:Sëmundje te veshkave. Simptoma të tilla si dobësia e muskujve ose rrahja e parregullt e zemrës (aritmi kardiake), Një gjendje e trajtuar me diuretikë ose ilaçe të zemrës. Ka presion të lartë të gjakut (hipertension) ose janë duke u trajtuar për presion të lartë të gjakut.
Panelet elektrolitike dhe panelet metabolike bazë zakonisht porositen në intervale të rregullta kur një mjek i kujdesit shëndetësor po diagnostikon ketoacidozë diabetike dhe sëmundje të veshkave ose kur monitoron një pacient që merr dializë, terapi diuretike ose lëngje intravenoze. Testimi i kaliumit në urinë mund të bëhet kur nivelet e kaliumit në gjak janë anormale.
Çfarë do të thotë rezultati i testit?Nivelet e kaliumit interpretohen në mënyrë tipike së bashku me rezultatet nga testet e tjera të bëra në të njëjtën kohë, siç janë rezultatet e testeve të tjera të elektroliteve. Nivelet e ulëta dhe të larta të kaliumit mund të shkaktohen nga kushte dhe sëmundje të ndryshme.![]() Shembuj të kushteve që mund të shkaktojnë nivele të larta kaliumi (hiperkalemia) përfshijnë:Sëmundja e veshkave, Sëmundja Addison, Lëndimi i indeve, Infeksioni, Diabeti, DehidrimiKonsumimi shumë i kaliumit (p.sh., dieta me kalium, shtesa kaliumi), Trajtimi me lëngje intravenoze (IV), kalium i tepruar IV. Përdorimi i barnave të caktuara që shkaktojnë kalium të lartë në një përqindje të vogël të njerëzve, duke përfshirë barna anti-inflamatore jo-steroide (NSAIDs), ACE frenues, beta bllokuesit (të tilla si propranolol dhe atenolol), frenues të enzimës konvertuese të angiotenzinës (të tilla si kaptopril, enalapril , dhe lisinopril), dhe diuretikë që kursejnë kalium (të tilla si triamterene, amiloride dhe spironolactone)
Shembuj të kushteve që mund të shkaktojnë nivele të larta kaliumi (hiperkalemia) përfshijnë:Sëmundja e veshkave, Sëmundja Addison, Lëndimi i indeve, Infeksioni, Diabeti, DehidrimiKonsumimi shumë i kaliumit (p.sh., dieta me kalium, shtesa kaliumi), Trajtimi me lëngje intravenoze (IV), kalium i tepruar IV. Përdorimi i barnave të caktuara që shkaktojnë kalium të lartë në një përqindje të vogël të njerëzve, duke përfshirë barna anti-inflamatore jo-steroide (NSAIDs), ACE frenues, beta bllokuesit (të tilla si propranolol dhe atenolol), frenues të enzimës konvertuese të angiotenzinës (të tilla si kaptopril, enalapril , dhe lisinopril), dhe diuretikë që kursejnë kalium (të tilla si triamterene, amiloride dhe spironolactone)![]() Shembuj të kushteve që mund të shkaktojnë nivele të ulëta të kaliumit (hipokalemia) përfshijnë:Diare dhe të vjella , Hiperldosteronizmi primar (sindroma Conn), Një ndërlikim i mbidozës së acetaminofenit, Diabeti – niveli i kaliumit mund të bjerë pasi të merrni insulinë, veçanërisht nëse nuk e keni menaxhuar mirë diabetin tuaj , Si efekt anësor i “pilulave të ujit” (diuretikë që harxhojnë kalium); nëse i merrni këto, ofruesi juaj i kujdesit shëndetësor mund të kontrollojë rregullisht nivelin tuaj të kaliumit, përdorimi i barnave të caktuara si kortikosteroidet, agonistët beta-adrenergjikë si izoproterenoli, antagonistët alfa-adrenergjikë si klonidina, antibiotikët si gentamicina dhe karbenicilina dhe agjenti antifungal amfotericina B.
Shembuj të kushteve që mund të shkaktojnë nivele të ulëta të kaliumit (hipokalemia) përfshijnë:Diare dhe të vjella , Hiperldosteronizmi primar (sindroma Conn), Një ndërlikim i mbidozës së acetaminofenit, Diabeti – niveli i kaliumit mund të bjerë pasi të merrni insulinë, veçanërisht nëse nuk e keni menaxhuar mirë diabetin tuaj , Si efekt anësor i “pilulave të ujit” (diuretikë që harxhojnë kalium); nëse i merrni këto, ofruesi juaj i kujdesit shëndetësor mund të kontrollojë rregullisht nivelin tuaj të kaliumit, përdorimi i barnave të caktuara si kortikosteroidet, agonistët beta-adrenergjikë si izoproterenoli, antagonistët alfa-adrenergjikë si klonidina, antibiotikët si gentamicina dhe karbenicilina dhe agjenti antifungal amfotericina B.
Nivelet e kaliumit ne urinë zakonisht krahasohen me nivelet e gjakut. Trupi normalisht eliminon kaliumin e tepërt, kështu që niveli i tij ne urinë mund të rritet sepse është i ngritur në gjak. Kaliumi i urinës mund të rritet gjithashtu kur trupi po humbet shumë kalium. Në këtë rast, niveli i gjakut do të ishte normal nga i ulët. Nëse nivelet e kaliumit në gjak janë të ulëta për shkak të moskonsumimit të mjaftueshëm, atëherë përqendrimet e urinës do të jenë gjithashtu të ulëta. Ulja e niveleve të kaliumit në urinë mund të jetë për shkak të barnave të caktuara si NSAID, beta bllokuesve dhe litium ose për shkak të gjëndrave mbiveshkore që prodhojnë shumë pak të hormonit aldosteron.Nivelet e rritura të kaliumit në urinë mund të vijnë për shkak të sëmundjes së veshkave, çrregullimeve të të ngrënit si anoreksia ose dëmtimi i muskujve.
• Rezultati juaj i kaliumit interpretohet nga mjeku juaj i kujdesit shëndetësor brenda kontekstit të testeve të tjera që keni bërë, si dhe faktorëve të tjerë, siç është historia juaj mjekësore. Një rezultat i vetëm i lartë ose i ulët mund të ketë ose nuk ka rëndësi mjekësore. Në përgjithësi, ky është rasti kur vlera e provës është vetëm pak më e lartë ose më e ulët se diapazoni i referencës. Kjo është arsyeja pse praktikuesit e kujdesit shëndetësor mund të përsërisin një test mbi ju dhe pse ata mund të shikojnë rezultate nga kohërat e mëparshme kur ju keni kryer të njëjtin test.Nga ana tjetër, një rezultat jashtë norms mund të tregojë një problem dhe të kërkojë hetime të mëtejshme.
• Cilat janë trajtimet e duhura për shkaqet e zakonshme të kaliumit të ulët (hipokalemia) dhe kaliumit të lartë (hiperkalemia)?Trajtimi për kalium të ulët mund të përfshijë marrjen e suplementeve të klorurit të kaliumit dhe ngrënien e më shumë ushqimeve të pasura me kalium, të tilla si banane, mishe viçi ose spinaq , pjepër, grejfrut, portokall, domate, pjepra , kunguj , patate, bishtajore, arra dhe fara janë gjithashtu burime të mira të kaliumit. Trajtimi për kalium të lartë mund të përfshijë përdorimin e diuretikëve, dializës së veshkave ose injeksioneve të insulinës.
• Nivelet e kaliumit mund të ngrihen në mënyrë të gabuar nga një sërë rrethanash që lidhen me mbledhjen e mostrave dhe përpunimin e mostrave. Për shembull, nëse shtrëngoni dhe relaksoheni grushtin tuaj në mënyrë të përsëritur ndërsa tërhiqet mostra e gjakut, niveli i kaliumit në gjak mund të rritet. Nëse mostrat e gjakut vonohen për të arritur në laborator ose nëse tubat e gjakut i nënshtrohen një trajtimi të ashpër gjatë tranzitit, kaliumi mund të rrjedhë nga qelizat e kuqe të gjakut dhe të ngrejë në mënyrë të gabuar kaliumin në serum. Një praktikues i kujdesit shëndetësor mund të vërë në dyshim rezultatet e ngritura të kaliumit kur numrat nuk përshtaten me gjendjen klinike. Nëse ka ndonjë pyetje se si është mbledhur gjaku, mjeku i kujdesit shëndetësor mund të kërkojë që testi të përsëritet për të verifikuar rezultatet.
• Testet shoqeruese per elektrolitet tjere jane |Klorur, Natriumi, Bikarbonat (gjithsej CO2), Elektrolitet dhe Anion Gap, Paneli Metabolik Themelor (BMP), Paneli Gjithëpërfshirës Metabolik (CMP), Aldosteroni dhe Renina
• Semundjet te te cilat duhet te kontrollohen ne menyre rutinore keto test e jane Hipertensioni, Acidoza dhe Alkaloza, Sëmundja e veshkave, Sëmundje të zemrës, Aldosteronizmi Primar (Sindroma Conn), Pamjaftueshmëria veshkave dhe sëmundja Addison.
Në mënyrë të saktë të gjitha testime mund ti bëni në Olive Medical & Laboratory dhe njëkohësisht të konsultoheni me mjekun familjar për të marrë orientimin e duhur për parandalimin dhe trajtimin.
Shkruan: Dr. Valbone Blaku, specialiste e Mjekësisë Familjare, staf në OML

10 maji i vitit 2021 shënon Ditën Botërore të Lupusit që është një problem global shëndetësor që prek miliona njerëz. Ne do ta mbështesim këtë fushatë ndërgjegjësimi duke shkëmbyer informacione mbi lupus.
Lupus është një sëmundje kronike, inflamatore autoimune. Eshtë një gjendje në të cilën sistemi imunitar, i cili normalisht mbron trupin nga infeksionet, prodhon një përgjigje të papërshtatshme imunitare kundër indeve të veta.
Lupus mund të ndikojë në lëkurën, nyjet, enët e gjakut dhe organet e brendshme, veçanërisht veshkat, zemrën, mushkëritë dhe trurin. Ekzistojnë disa lloje të lupusit; më e zakonshme është lupus erythematosus sistemik (LES ), i cili prek shumë zona të trupit. Çdokush mund të kete lupus në çdo kohë, por më së shpeshti prek gratë në moshë të lindjes së fëmijëve. LES shihet më shpesh te njerëzit midis moshës 15 dhe 44 vjeç, megjithëse fëmijët, përfshirë të porsalindurit, dhe të rriturit më të vjetër gjithashtu mund të kenë lupus.
Shkaku i lupus nuk është kuptuar plotësisht. Mendohet se përfshin një përbërës të trashëguar dhe një shkas që mund të lidhet me faktorët e mjedisit, siç është ekspozimi ndaj dritës së diellit, ose përdorimi i disa ilaçeve dhe infeksioneve virale. Lupus mund të bashkëjetojë me çrregullime të tjera autoimune, të tilla si sindroma Sjögren, disa raste të anemisë hemolitike, tiroiditi Hashimoto dhe purpura trombocitopenike idiopatike (ITP ose qrregullimet e Gjakut – qrregullimet e trombociteve).
Ka shumë lloje të lupusit. Disa nga këto janë renditur më poshtë:
- Lupus eritematoz sistemik (LES)
- Lupus Discoid
- Lupus i shkaktuar nga medikamentet
- Lupus neonatal
Shenjat dhe simptomat e lupus ndryshojnë nga personi në person dhe nga lloji i lupusit.Njerëzit me lupus mund të zhvillojnë një skuqje, siç janë:
• Një skuqje që i ngjan një fluture që shfaqet përgjatë hundës dhe faqeve (skuqje malare)
• Një skuqje që përbëhet nga copëza të rrumbullakëta ose ovale (skuqje discoid)
• Një skuqje në zonat e lëkurës që janë të ekspozuara në rrezet e diellit (zakonisht fytyrën dhe ekstremitetet)
• Një skuqje është zakonisht simptoma e vetme në lupusin e lëkurës discoid dhe subakut. Njerëzit me lloje të tjera të lupus mund të kenë një kombinim të shenjave dhe simptomave shtesë vijuese:
• Dhimbje muskulore, Dhimbje e ngjashme me artritin në një ose më shumë nyje (por nuk ka ose pak dëmtime të përbashkët)
• Ethe, Lodhje e vazhdueshme, Nyjet limfatike të fryra, Ndjeshmëri ndaj dritës së diellit
• Fenomeni i Raynaud (gishtat ndryshojnë ngjyrën pas ekspozimit ndaj temperaturave të ftohta ose me stres)
• Renia e flokeve ,Dhimbje gjoksi, Anemi, Ulçera të gojës
• Inflamacion dhe dëmtim i organeve dhe indeve, përfshirë veshkat, mushkëritë, zemrën, rreshtimin e zemrës, sistemin nervor qendror dhe enët e gjakut
Të gjitha analizat laboratorike të nevojshme për të vendosur diagnozën si dhe për të lehtësuar tretmanin ju mund ti bëni në Olive Medical & Laboratory.

- Ndryshimet e ngjyres në lëkurën tuaj si përgjigje ndaj të ftohtit ose stresit
- Ndjesia e mpirjes , gjembave ose dhimbjes therëse pas ngrohjes ose lehtësimit të stresit
- Gjatë një sulmi të Raynaud, zonat e prekura të lëkurës suaj zakonisht bëhen të bardha,pastaj, ato shpesh bëhen blu dhe ndjehen të ftohtë dhe të mpirë.
- Ndërsa ngroheni dhe qarkullimi juaj përmirësohet , zonat e prekura mund të bëhen të kuqe, kan pulsim, ndjesi shpimi ose fryrje.
- Edhe pse Raynaud prek më shpesh gishtat e duarve dhe këmbëve, mund të prekë edhe zona të tjera të trupit, të tilla si hunda, buzët, veshët dhe madje edhe thimthat. Pasi të ngroheni, kthimi i rrjedhjes normale të gjakut në zonë mund të zgjasë 15 minuta.
Shkaqet

Faktori reumatoid (RF) është një autoantibody, një proteinë imunoglobulin M (IgM) që prodhohet nga sistemi imunitar i trupit. Autoantitrupat sulmojnë indet e veta të një personi, duke e identifikuar gabimisht indin si “të huaj”. Ndërsa roli biologjik i RF nuk është kuptuar mirë, prania e tij është e dobishme si një tregues i aktivitetit inflamator dhe autoimun. Ky test zbulon dhe mat RF në gjak dhe mund të përdoret, së bashku me testet e tjera, për të ndihmuar në diagnostikimin e artritit reumatoid (RA).RA është një sëmundje kronike, sistemike autoimune që shkakton inflamacion, dhimbje, ngurtësi dhe ndryshime destruktive në duar, këmbë dhe nyje të tjera në të gjithë trupin. Disa pacientë mund të tregojnë shenja të lodhjes, ethe të shkallës së ulët dhe humbje peshe.Mund të prekë cilindo në çdo moshë, por zakonisht zhvillohet në vitet e vona të lindjes së fëmijëve në gra dhe midis moshave 60 deri në 80 vjeç tek burrat. Mbi 70% e të prekurve me RA janë gra. Kursi i RA dhe prognoza e tij janë të ndryshueshme. Mund të zhvillohet dhe përparojë ngadalë ose me shpejtësi. Mund të shkojë në heshtje te disa njerëz dhe per pak mund të largohet. Nese mbetet i patrajtuar, RA mund të shkurtojë jetëgjatësinë e një personi dhe brenda disa viteve mund të lërë shumë prej atyre që preken shumë me aftësi të kufizuara të punojnë.Ekzistojnë një larmi trajtimesh në dispozicion për të minimizuar komplikimet e RA, por ato varen nga bërja e një diagnoze të saktë dhe nga fillimi i trajtimit para zhvillimit të dëmtimeve të rëndësishme të kyçeve.Faktori reumatoid është përdorur për të zbuluar RA.Për shkak se ndjeshmëria dhe specifikimi i RF nuk janë ideale, testet e tjera laboratorike shpesh kryhen së bashku me testimin RF. Rreth 80% e atyre me RA do të kenë një test pozitiv RF, por mund të jetë negativ në njerëzit që kanë shenja klinike të RA. Një test për antitrupat peptid ciklik citrullinuar (CCP) mund të bëhet së bashku me një test RF pasi studimet kanë treguar që testi i antitrupave CCP ka një ndjeshmëri dhe specifikë që konsiderohet më mirë se RF dhe ka më shumë të ngjarë të jetë pozitive me RA të hershme.
Teste të tjera që mund të kryhen janë:
- Numërimi i plotë i gjakut (CBC, për anemi dhe trombocitozë)
- Shkalla e sedimentimit të eritrociteve (ESR)
- Proteina reaktive C (CRP)
- Antitrupat anti-bërthamorë (ANA)
- Antitrupat citoplazmikë antineutropil (ANCA)
- Analiza e lëngut synovial (nyjet inflamatore)
RF e ngritur mund të gjendet në një përqindje të vogël (5-10%) të njerëzve të shëndetshëm. RF gjithashtu mund të rritet në të moshuarit, megjithëse mund të mos tregojnë shenja klinike. Për më tepër, nivelet e ngritura të RF mund të zbulohen te njerëzit që nuk kanë RA (pozitive false), por mund të kenë një çrregullim tjetër si Sindroma Sjögren, Lupus eritematoz sistemik, Infeksione bakteriale, virale dhe parazitare (hepatiti, TB, sifilisi, lebra), Disa kancere, Sëmundje te mushkërive, sëmundje te mëlçisë dhe sëmundjen e veshkave.
Testi i faktorit reumatoid (RF) përdoret në lidhje me testet e tjera laboratorike dhe testet e imazheve (rrezet X, ultratinguj, MRI) për të diagnostikuar artritin reumatoid (RA) dhe për të ndihmuar në dallimin e RA nga format e tjera të artritit ose kushteve të tjera që shkaktojnë simptomat të ngjashme
Ndërsa diagnoza e RA mbështetet shumë në tablonë klinike, disa nga shenjat dhe simptomat mund të mos jenë të pranishme ose të ndjekin një model tipik, veçanërisht në fillim të sëmundjes. Për më tepër, shenjat dhe simptomat mund të mos jenë gjithmonë të identifikueshme qartë pasi që njerëzit me RA mund të kenë edhe çrregullime ose kushte të tjera të indit lidhës, siç janë fenomeni Raynaud, skleroderma, çrregullimet autoimune të tiroides, dhe eritematoza sistemike e lupusit, si dhe shfaqin simptoma të këtyre çrregullimeve. Testi RF është një mjet ndër të tjerët që mund të përdoret për të ndihmuar në bërjen e një diagnoze kur RA dyshohet. Testi për RF mund të porositet kur një person ka shenja dhe simptoma të RA. Simptomat mund të përfshijnë: Dhimbje, ngrohtësi, ënjtje dhe ngurtësi në mëngjes në nyje, Nyjet nën lëkurë .Nëse sëmundja ka përparuar, prova me rrezet X identifikon gungat e fryra të nyjeve dhe humbjen e kërcit dhe kockave Testi RF duhet të interpretohet në lidhje me testet e më shumë laboratorike dhe shenjat, simptomat dhe historinë klinike të një personi. RF është e vendosur në 70% -90% të pacientëve me RA, megjithëse nuk është diagnostikues i RA.Në PACIENTAT me simptoma dhe shenja klinike të artritit reumatoid, prania e dhe vlerësimi i RF-së ka të ngjarë që ata të kene RA. Nivelet e RF në përgjithësi lidhen me sëmundjen më të rëndësishme dhe një prognozë më të mirë.Një provë negative per RF nuk ekziston RA. Në të vërtetë, një test i antitrupave CCP mund të jetë pozitiv për të konfirmuar RA. Kriteret e Klasifikimit të Artritit Reumatoid nga Kolegji Amerikan i Rheumatologjisë (ACR) përfshin testimin e antitrupave ceptik të citrullinuar (CCP) të antitrupave, së bashku me RF, si pjesë e kritereve të tij për diagnostikimin e artritit reumatoid. Sipas ACR, antitrupat CCP mund të zbulohen në rreth 50-60% të njerëzve me RA të hershme, qysh në 3-6 muaj pas fillimit të simptomave. Zbulimi i hershëm dhe diagnostikimi i RA lejon praktikuesit e kujdesit shëndetësor që të fillojnë trajtimin agresiv të gjendjes, duke minimizuar komplikimet e lidhura dhe dëmtimin e indeveKjo varet nga laboratori që kryen testin. Jo çdo laborator e kryen këtë test dhe mostra juaj mund të dërgohet në një laborator referencë për testim. Mund të duhen 2 deri në 3 ditë që rezultatet të jenë në dispozicion.Testet Anti CCP ,ANA ,ESR,CRP ,CBC, Autoantitrupat ,ANCA/MPO/PR3,ENA paneli Sqarime per shkurtesat Cyclic Citrullinated Peptide Antibody- anti CCP, Antinuclear Antibody (ANA), Erythrocyte Sedimentation Rate (ESR), C-Reactive Protein (CRP), Autoantibodies, Complete Blood Count (CBC), Antineutrophil Cytoplasmic Antibodies (ANCA, MPO, PR3), Conditat/patologjite –Arthritis rheumatoid ,Semundjet autoimmune.
Rezultatet e testit të fibrinogjenit raportohen si përqendrimi i proteinës në gjak. Testet e aktivitetit të fibrinogjenit shndërrohen në përqendrime për krahasim me rezultatet e antigjenit fibrinogjen. Rezultatet zakonisht interpretohen në kontekstin e rezultateve nga testet e tjera.Rezultatet e aktivitetit normal të fibrinogjenit zakonisht pasqyrojnë kontributin normal të fibrinogjenit në aftësinë tuaj të koagulimit të gjakut.Aktiviteti i ulur ndjeshëm i fibrinogjenit mund të jetë për shkak të një sasie të ulur të fibrinogjenit ose fibrinogjenit që nuk funksionon ashtu siç duhet. Aktiviteti i ulur i fibrinogjenit dhe niveli i antigjenit mund të ndikojnë në aftësinë tuaj për të formuar një mpiksje të qëndrueshme të gjakut.
Nivele të ulëta të fibrinogjenit që vazhdojnë me kalimin e kohës (kronike) mund të lidhen me paaftësinë e trupit për të prodhuar fibrinogjen për shkak të:Një gjendje e fituar siç është sëmundja e mëlçisë në fazën e fundit ose kequshqyerja e rëndë. Një gjendje e rrallë e trashëguar si disfibrinogenemia, afibrinogenemia ose hipofibrinogenemia .Nivele të ulëta akut shpesh lidhen me kushtet në të cilat fibrinogjeni përdoret më shpejt se sa trupi mund ta prodhojë atë. Kjo mund të ndodhë me koagulimin e shpërndarë intravaskular (DIC) dhe fibrinolizën anormale, e cila ndodh kur trupi është tepër aktiv në prishjen dhe pastrimin e mpiksjes së gjakut.Nivelet e ulura të fibrinogjenit gjithashtu mund të ndodhin pas transfuzioneve të shpejta, të vëllimit të madh.
Ndonjëherë një mjek i kujdesit shëndetësor do të përdorë një raport të testit të antigjenit dhe testit të aktivitetit. Kjo do të ndihmojë për të dalluar fibrinogjenin jofunksional (raport të lartë) nga fibrinogjeni i ulët (raporti afër 1). Fibrinogen është një reaktant i fazës akute, që do të thotë që niveli i fibrinogjenit mund të rritet ndjeshëm në çdo gjendje që shkakton inflamacion ose dëmtim të indeve. Nivelet e larta të fibrinogjenit nuk janë specifike. Ata nuk i tregojnë mjekut të kujdesit shëndetësor shkakun ose vendndodhjen e inflamacionit ose dëmtimit. Zakonisht këto nivele të rritura janë të përkohshme, duke u kthyer në normale pasi të zgjidhet gjendja themelore.Niveli i rritur i fibrinogjenit mund të shihet me:infeksionetkancer ,Sëmundja koronare e zemrës, sulmi në zemër, goditje , rregullime inflamatore (si artriti reumatoid dhe glomerulonefriti, një formë e sëmundjes së veshkave) ,trauma, Sëmundja e arteries periferike, Pirja e duhanit. Ndërsa nivelet e fibrinogjenit janë ngritur, rreziku i një personi për të zhvilluar një mpiksje gjaku mund të rritet dhe, me kalimin e kohës, ato mund të kontribuojnë në një rrezik të rritur për sëmundje kardiovaskulare

Alergjitë janë mbindjeshmëri të sistemit imunitar ndaj substancave që nuk shkaktojnë reaksione te shumica e njerëzve. Substancat që shkaktojnë mbindjeshmëri quhen alergjene. Pothuajse 50% te të gjithë njerezit në të gjithë botën shfaqin një lloj reagimi alergjik ndaj të paktën një lloj ushqimi, insekti, droge, bime ose kafshe. Derisa dikush mund të zhvillojë një alergji edhe anëtarët tjerë të familjes janë në një rrezik të rritur për të pasur një alergji. Një person që është “i predispozuar”megjithatë, nuk mund të reagojë ndaj të njëjtave substanca si prindërit dhe motrat e tij ose të saj. Kjo gjë varet nga ajo qfarë alergjeni i ekspozohet personit dhe përgjigja e sistemit imunitar të këtij personi.
Hipersensitivitetet grupohen në dy lloje I dhe IV. Këto klasifikime bazohen, në një farë mase, në cilat pjesë të sistemit imunitar janë aktivizuar dhe sa kohë duhet që të ndodhë një reagim. Të dy llojet e hipersensitivitetit që zakonisht shoqërohen me termin “alergji” janë:
1. Hipersensitiviteti i menjëhershëm i tipit I – njerëzit me këto lloje alergjish prodhojnë proteina imune të quajtur antitrupa kur ekspozohen ndaj një alergeni. Klasa e antitrupave të prodhuar quhet imunoglobulinë E (IgE). Kur këto antitrupa lidhen me alergjenët, ato shkaktojnë reaksione lokale dhe ndonjëherë reagime që prekin tërë trupin, zakonisht brenda disa minutash.
2.Hipersensitivitetet e vonuara të tipit IV – këto reaksione shkaktohen nga ndërveprimet e alergeneve me qelizat imune të sensibilizuara specifike, qelizat e bardha të gjakut të quajtura limfocitet T.
1.Tipi I – Hipersensitivitetet e tipit i prekin kryesisht sistemet e frymëmarrjes , gastrointestinale dhe lëkurën. Herën e parë që një person i predispozuar i ekspozohet një alergeni të mundshëm, ai person nuk do të ketë një reagim të madh por do të fillojë prodhimin e antitrupave IgE drejtuar kundër alergjenit specifik (antitrupa IgE specifike për alergjenin). Pasi dikush të sensibilizohet në këtë mënyrë, ekspozimet pasuese mund të rezultojnë në reagime të rënda. Antitrupa IgE e prodhuar si përgjigje ndaj një alergjeni lidhet me qelizat master, qelizat e specializuara në inde dhe bazofilet në rrjedhën e gjakut. Ky veprim mbron sistemin imunitar. Gjatë ekspozimit pasues ndaj alergjenit IgE i kufizuar specifik e njeh alergjenin, lidhet me të dhe shkakton lëshimin e kimikateve, përfshirë histaminën, duke shkaktuar simptoma alergjike që mund të fillojnë në gojë, hundë, apo në lëkurë, kudo që ky alergjen eshte prezent. Reagimet alergjike të tipit I mund të ndryshojnë në ashpërsi duke shkaktuar se pari një skuqje të kuqe ose urtikarie , herën tjetër një reagim akut serioz dhe kërcënues për jetën, të quajtur anafilaksë. Anafilaksia është një reagim multi-organik që mund të fillojë me agjitacion, një ndjenjë të “mbytjes”, lëkurë e zbehtë për shkak të presionit të ulët të gjakut, dhe humbje e vetëdijes (ligështimit). Anafilaksia mund të jetë fatale pa administrimin e shpejtë të një injeksioni epinephrine (adrenalinë). Alergjitë e tipit I mund të jenë si përgjigje në një larmi substancash, por jo te kufizuara vetëm në këto si ushqimet, bimë si polenet, barërat e këqija, helmet e insekteve, pështyma e kafshëve , maceve, qenëve, marimangat e pluhurit ,sporet e mykut, substancat profesionale si (latex), droga të tilla si penicilina. Mund të ketë edhe reaksione të kryqëzuara, kur dikush është alergjik ndaj bimës së lëpushës, për shembull, gjithashtu mund të reagojë ndaj pjepërit , shalqirit , kanellës dhe bananes. Shkaqet më të zakonshme të reaksioneve të rënda anafilaktike që lidhen me ushqimin janë kikirikët, arrat.
2.Lloji IV/ Hipersensitivitetet e tipit IV zakonisht përfshijnë lëkurën dhe përcaktohen si hipersensitivitete “të vonuara” pasi reagimi zakonisht shfaqet rreth 48-72 orë pas ekspozimit ndaj një alergjeni. Këto reaksione ndodhin kur një alergjen bashkëvepron me limfocitet T të sensibilizuara specifike. Limfocitet lëshojnë substanca inflamatore dhe toksike, të cilat tërheqin qelizat e tjera të bardha të gjakut në vendin e ekspozimit, duke rezultuar në dëmtim të indeve. Njerëzit mund të kenë një reaksion të tipit IV me ekspozimin e parë. Një shembull i zakonshëm i këtij lloji të alergjisë është reagimi ndaj dredhëza helmuese.
Cfarë nuk është një alergji? – Ka reagime të tjera që mund të shkaktojnë simptoma të ngjashme me alergjinë , por që nuk shkaktohen nga një aktivizim i sistemit imunitar. Ato variojnë nga reaksione toksike që prekin këdo që ka ekspozim të mjaftueshëm, siç është helmimi nga ushqimi i shkaktuar nga toksinat bakteriale, deri tek kushtet gjenetike, siç janë intolerancat e shkaktuara nga mungesa e një enzimë (për shembull, pamundësia për të tretur sheqerin, duke rezultuar me intoleranc ne laktozë dhe ndjeshmëria ndaj gjërave qe permbajne gluten si në sëmundjen Celiace. Simptomat mund të shkaktohen nga medikamente të tilla si aspirina dhe ampicilina, ngjyra ushqimore si glutamat monosodium qe eshte një shtues aromë ushqimi, dhe nga disa shkaktues psikologjikë. Këto sëmundje dhe kushte mund të kenë nevojë të hetohen nga një mjek shëndetësor, ato nuk janë alergji dhe nuk do të identifikohen gjatë testimit të alergjisë.
Testimi laboratorik për reaksionet alergjike mund të përfshijë:
Testimi i gjakut specifik për alergjin IgE: ky është testi që përdoret për të ndihmuar në diagnostikimin e alergjive. Testi mat sasinë e antitrupave IgE specifike për alergjen në gjak në mënyrë që të zbulojë një alergji ndaj një substance të veçantë. Ai përfshin marrjen e një mostre gjaku dhe kontrollin për secilin alergjen të dyshuar. Alergjenet mund të zgjidhen një nga një ose duke zgjedhur panele siç janë panelet ushqimore, të cilat përmbajnë alergjenët më të zakonshëm të ushqimit për të rritur ose fëmijë, dhe panelet e barërave, pastaj alergjenët më të zakonshëm të ajrit në vendin ku jeton personi. Zgjedhjet individuale janë shumë specifike; për shembull: bleta e egër kundrejt bletës së mjaltit, e bardha e vezëve kundrejt të verdhës së vezës, merimangat , dermatofaget etj. Mjeku do të zgjedhë alergjenët më të përshtatshëm. Zakonisht dikush do të jetë vërtet alergjik ndaj disa substancave (4 ose më pak). Nëse një test specifik IgE është negativ, atëherë shanset janë që personi i testuar të mos jetë alergjik ndaj asaj substance, por një test pozitiv duhet të vlerësohet në kontekstin e historisë klinike të personit. Dikush mund të ketë një nivel të ulët të IgE dhe akoma ka një reagim të ashpër ndaj ekspozimit aktual ndaj alergjenit ose një niveli të ngritur dhe kurrë mos të përjetojë një reagim. Fëmijët të cilët tejkalojnë një alergji ushqimore mund të vazhdojnë të kenë rezultate pozitive të testit IgE për shumë vite.Shënim: Metoda tradicionale për testimin e gjakut ishte RAST (testi radioallergosorbent), por ai është zëvendësuar kryesisht me metodat më të reja të imunitetit të IgE-specifik.
Testimi i IgE total ndonjëherë bëhet për të kërkuar një proces alergjik në vazhdim. Eshtë një test gjaku që zbulon sasinë totale të proteinës IgE (përfshirë antitrupa alergjie), por nuk identifikon alergene specifike. Përveç alergjive ka edhe kondita tjera qe mund të bëjnë që niveli i IgE të rritet.
Numërimi i plotë i gjakut (CBC) dhe ËBC diferencial — këto teste përfshijnë edhe matjen e eozinofileve, një lloj qelizash të bardha të gjakut. Niveli i eozinofileve mund të rritet në një person me alergji.
Testet e gjakut të histaminës dhe triptazës mund të përdoren për të ndihmuar në diagnostikimin e anafilaksës ose aktivizimit të qelizave mast
Sfidat me ushqime orale konsiderohen “standardi i artë” për diagnostikimin e alergjive ushqimore. Ato kërkojnë mbikëqyrje të ngushtë mjekësore, sepse reagimet mund të jenë të rënda, duke përfshirë anafilaksinë kërcënuese për jetën. Sfidat ushqimore përfshijnë dhënien te një person sasi të vogla të alergeneve potenciale ushqimore të pa shënjuara në kapsulë ose formë intravenoze dhe të shikoni për reaksione alergjike. Negativët konfirmohen me dhenjen e sasive me të mëdha të ushqimit.
Eliminimi i ushqimit është një mënyrë tjetër për të provuar për alergjitë ushqimore: eliminimi i të gjitha ushqimeve të dyshuara nga dieta, pastaj rivendosja e tyre një në një kohë për të zbuluar se cilat janë duke shkaktuar problemin. Shmangia dhe Eliminimi-Pasi të jetë zhvilluar një alergji, mënyra më e mirë për të parandaluar një reagim është parandalimi i ekspozimit kudo që të jetë e mundur.
Desensitizimi (imunoterapia, terapi specifike imune, ndonjëherë rekomandohet nëse nuk mund të shmanget alergjeni. Ai përfshin injeksione të rregullta të alergjenit, të dhëna në doza në rritje që mund të “stimulojnë” trupin ndaj alergjenit. Keto ulin sasinë e antitrupave IgE në gjak dhe bëjnë që trupi të bëjë një antitrup mbrojtës, një tjetër nga imunoglobulinat, IgG por kjo praktikohet vetëm nga specialistët e Alergologjisë.
Në mënyrën më të përsosur dhe me metodat më të avancuara aktualisht në vendin tonë këto testime i realizojmë ne në Olive Medical & Laboratory
Të kujdesesh çdoherë për trupin tënd e t’i kryesh analizat e duhura çdo vit, është çelësi për një jetë më të gjatë e të shëndetshme.
T‘i kryesh analizat e trupit e të gjakut me rregull do të thotë të kujdesesh për mirëqenien tënde.
Ka arsye të shumta pse duhet ta ekzaminosh gjendjen e trupit tënd e ato janë:![]() Kur keni një simptomë jo të zakontë
Kur keni një simptomë jo të zakontë![]() Të kuptoni më shumë mbi gjendjen tuaj shëndetësore
Të kuptoni më shumë mbi gjendjen tuaj shëndetësore![]() Dëshironi t’i parandaloni rreziqet e mundshme nga ndonjë sëmundje.
Dëshironi t’i parandaloni rreziqet e mundshme nga ndonjë sëmundje.
Janë disa rregulla të cilat duhet t’i ndiqni përpara se të bëni analiza.![]() Është e rëndësishme që të abstenoni nga ushqimi 8 deri në 12 orë përpara analizave, në mënyrë që rezultatet të jenë sa më të vërteta.
Është e rëndësishme që të abstenoni nga ushqimi 8 deri në 12 orë përpara analizave, në mënyrë që rezultatet të jenë sa më të vërteta.![]() Kur keni në plan të bëni analizat e kolesterolit, sheqerit, mëlçisë e të veshkave duhet të keni parasysh që të mos hani asgjë gjatë kësaj periudhe.
Kur keni në plan të bëni analizat e kolesterolit, sheqerit, mëlçisë e të veshkave duhet të keni parasysh që të mos hani asgjë gjatë kësaj periudhe.
Në mënyrë që rezultatet të dalin reale dhe pa ndonjë lëshim, vizitoni ‘Olive Medical&Laboratory”.
Këto analiza bëhen pa pasur nevojë që pacienti të shkojë jashtë vendi pasi “Olive Medical&Laboratory”, është i vetmi në rajon që punon me protokole diagnostike të: biokimisë klinike dhe mjekësore gjermane. Mbi të gjitha ky vend monitorohet nga “Referenzinstitut fuer Bioanalytik”, që gjendet në Bonn të Gjermanisë.

